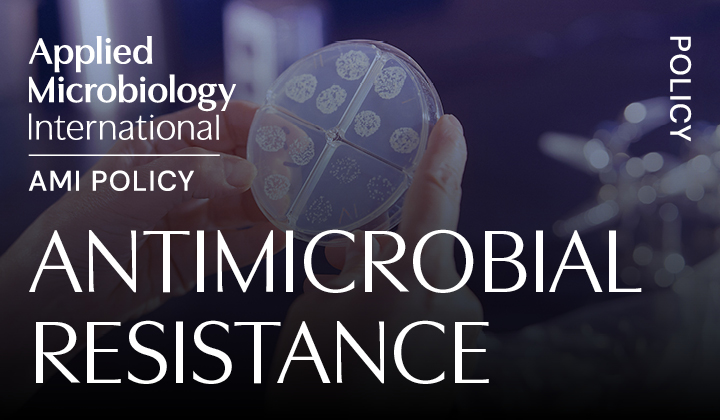
Policy_Thumbnail03.png

Policy
AMI’s Policy Team works with our members to ensure microbiology informs the choices of decision-makers across the globe.
Who are the decision-makers?
Decision-makers are anyone with the power to act on something, from policymakers – those shaping laws, rules and regulations such as government officials – to hospital managers deciding which disinfectant to purchase or a farmer choosing whether to use an artificial or bio-fertiliser.
These individuals make choices that have ramifications across borders, sectors and all aspects of the One Health spectrum every day. Our role is to make sure microbiology is part of that conversation.
All areas within microbiology are relevant to our activities, but our work largely focuses on four main priority areas:
Find out how to get involved
 Proactive Work
Proactive Work
Discover how we drive change – from policy briefs to roundtables – engaging decision-makers on key microbiology issues.
 Reactive Work
Reactive Work
See how our members respond to global consultations and calls for evidence, bringing microbiology into policy discussions.
 Current Opportunities
Current Opportunities
Turn your expertise into impact - explore ways to get involved in AMI’s policy work. We’re always keen to have your involvement.
 Policy News
Policy News
Stay up to date with the latest developments in AMI’s policy work.
 Policy Events
Policy Events
Learn how the AMI Policy Team contributes to and influences important conversations by engaging in events that shape global policy and build partnerships.
 Policy On-demand
Policy On-demand
Explore past webinars bridging microbiology and policy.
 Policy Networks
Policy Networks
See who we partner with to amplify microbiology's voice in global decision-making.
 Science in Parliament Journal
Science in Parliament Journal
Access your exclusive member benefit and stay informed with Science in Parliament.